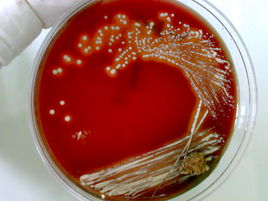
为什么别人的青春期没有痘痘?本期文章不藏私战痘好物起底

Hello大家好,我是星星。很多小伙伴都被痘痘困扰着,今天我们就来说一说痘痘肌应该怎样来护理。
偷偷告诉你,其实我也是个痘痘肌而且还是个敏感型的痘痘肌,附上痘痘照和现在基本无痘对比图镇文,另附本人再用好物推荐。

此图为iphone6s前置摄像头拍摄,五ps,无底妆。

痘痘,又名*疮痤**,也称寻常型*疮痤**。在毛囊被死皮细胞和来自皮肤的油脂堵塞时出现。特点:黑头、白头、疙瘩、油性皮肤可能会伴随疤痕。
· 皮脂腺发达:排出过多的皮脂,油脂腺发达的人不容易肥胖但更容易的粉刺

如果你是这种情况导致面部、背部出痘痘,下面有一些建议,可以有效地缓解你的症状:
1. 少吃油炸性食物
2. 每周定期清洁角质层,但切记过于频繁
3. 配合适当的运动,女孩子在运动的时候切记带妆,带妆运动容易堵塞毛孔。
4. 适当的为肌肤补水
5. 有些患者可能是缺乏维生素B族导致,可以根据医嘱来补充维生素B族(小红书也有用维生素B6来祛痘成功的案例,可供参考)
· 饮食不健康:使用过多高热量特别含过多油脂和刺激性食物

除了要健康饮食,戒掉油炸和辛辣等刺激性食物之外,还要做到饮食要少精致碳水(例如白米饭)、少食乳制品和脱脂牛奶。

· 内分泌失调:内分泌失调使得皮脂分泌过多,此与睡眠休息,压力和情绪有关
建议:
1. 合理规划作息,尽可能地早睡早起
2. 适当地释放自己的压力,不让精神状态紧绷。
3. 女性可在生理期的第三-四天(这个检验时间最准确)去医院对于自己的激素水平进行检测,查看致痘原因是否是由于雄性激素过高/雌性激素偏低引起。
· 毛囊角质化(Follicular hyperkeratinization):毛囊角质化导致皮脂腺的分泌物无法排出,进而导致毛囊破裂,发炎细胞浸润(inflammatory cells infiltration)

图1(左)为正常的毛孔,图二(右)为堵塞了的毛孔(患痘毛孔)
通过观察毛孔角质化的患肢后发现,通常在干燥的环境下(秋冬季),症状往往会恶化;而在潮湿一点的春夏,症状反而会改善。因此保湿是关键。
注意:
1. 清洁不要过度
2. 可以选用一些不含皂基的洁面产品
3. 避免用太烫的水清洗皮肤。
4. 选择保湿产品的时候尽量选择成分单纯的产品
5. 可以用以下产品调节角质代谢:果酸、水杨酸、外用A酸、尿素。
· *疮痤**丙酸杆菌滋生:*疮痤**丙酸杆菌将皮脂固化,促进发炎反应

*疮痤**丙酸杆菌(学名Propionibacterium acnes)是和皮肤疾病粉刺息息相关,是一种生长相对缓慢的典型革兰氏阳性厌氧菌(杆状)。
*疮痤**丙酸杆菌生活在我们毛孔里的脂肪酸上,当毛孔被堵塞时,它们就会疯狂生长,分解饱和脂肪酸,产生大量的游离脂肪酸,这些脂肪酸通过毛孔渗入皮肤,引起皮肤应激反应,产生粉刺、红肿等,葡萄状球菌等细菌通过流出的脓液粘在皮肤上,导致皮肤组织受损。利用过氧化苯甲酰和抗生素等很多抗菌药物可杀死*疮痤**丙酸杆菌。
· 消化系统问题:如果一个人长期出现便秘、慢性腹泻、胃酸过多、溃疡等情况,即出现消化系统问题。此时会导致体内毒素堆积,废物无法正常排出,这种情况常出现在嘴周长痘或是脸颊长痘。而如果消化系统这一根本问题没有得到改善,痘痘将会反复不断的长。

这个时候最重要的问题已经不仅仅是你的痘痘了,还有你的胃肠道哦~
· 皮肤角质受损:频繁的去角质/经常更换护肤产品,都会导致皮肤的屏障受损,从而导致痘痘的出现。

左侧为正常皮肤,右侧为屏障受损皮肤

你皮肤屏障处于"修复中",它本身防御功能很差,你涂修复品,其实是自己制造1层屏障。
此刻,用品不能拖后腿,用品不能用错。常见的修复屏障能用到的成分:

战痘物品相关推荐:
· 复方珍珠暗疮片:

中成药名。为清热剂,具有清热解毒,凉血消斑之功效。主治血热蕴阻肌肤所致的粉刺、湿疮,症见颜面部红斑、粉刺疙瘩、脓疱,或皮肤红斑丘疹、瘙痒;*疮痤**、红斑丘疹性湿疹见上述证候者。(建议遵医嘱)
· 资生堂红腰子

这一款精华不仅能够抗氧化、美白还能够修复受损的肌肤屏障,用了它之后我再也没有过敏过。(酒精过敏者慎用)
· 过氧化苯甲酰凝胶


这两款一个国产一个进口,我都在用过,并且正在用。
· 蒂佳婷V7激光霜

这一款激光霜其实是用来去斑的,但是我在痘痘消炎后去痘印的时候使用过两支,效果特别好,大概一周痘印完全不见。这一款是有趋光性的,建议晚上使用。